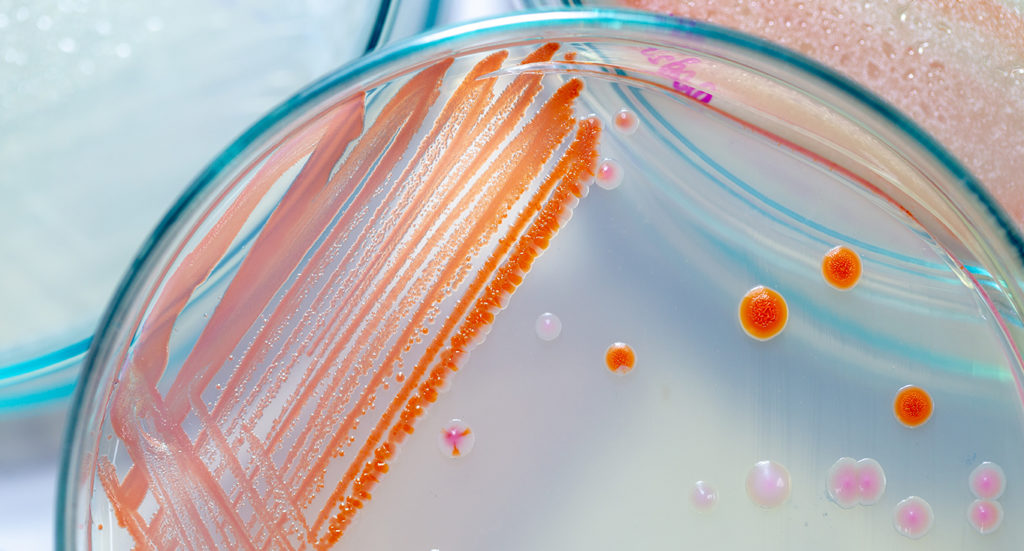

Palveluita kylpyhuoneen huolettomaan puhtaanapitoon
Ammattitaitoa ja kokemusta
Hohdepinnoitus Oy, vuonna 2017 perustettu yritys, on erikoistunut tarjoamaan ratkaisuja saniteettitilojen puhtauden ja kunnossapidon haasteisiin. Yrityksemme on yksi alan ensimmäisistä toimijoista, ja ylpeänä voimme todeta, että olemme rakentaneet vankkaa kokemusta tuhansien kohteiden parissa. Hohde Laatta -palvelukokonaisuus syntyi, kun halusimme tarjota asiakkaillemme helppoa tilojen puhtaanapitoa, joka myös pidentää tilojen käyttöikää merkittävästi.
Toimimme nykyisin muuan muassa seuraavilla paikkakunnilla: Turku, Raisio, Naantali, Rusko, Masku, Lieto, Kaarina, Espoo, Helsinki, Vantaa, Salo, Kirkkonummi, Veikkola, Paimio, Tampere, Nokia, Valkeakoski